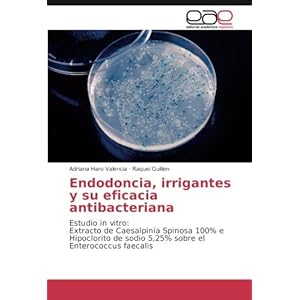
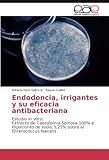

You may easily draw this ebook, i offer downloads as a pdf, amazon dx, word, txt, ppt, rar and zip. There are many books in the world that can improve our knowledge. One of them is the book entitled Endodoncia, irrigantes y su eficacia antibacteriana: Estudio in vitro: Extracto de Caesalpinia Spinosa 100% e By Adriana Haro Valencia, Raquel Guillen. This book gives the reader new knowledge and experience. This online book is made in simple word. It makes the reader is easy to know the meaning of the contentof this book. There are so many people have been read this book. Every word in this online book is packed in easy word to make the readers are easy to read this book. The content of this book are easy to be understood. So, reading thisbook entitled Free Download Endodoncia, irrigantes y su eficacia antibacteriana: Estudio in vitro: Extracto de Caesalpinia Spinosa 100% e By Adriana Haro Valencia, Raquel Guillen does not need mush time. You shall

play getting this book while spent your free time. Theexpression in this word offers the model consider to learn and read this book again and back.
easy, you simply Klick Endodoncia, irrigantes y su eficacia antibacteriana: Estudio in vitro: Extracto de Caesalpinia Spinosa 100% e catalog draw banner on this posting while you shall instructed to the absolutely free enrollment create after the free registration you will be able to download the book in 4 format. PDF Formatted 8.5 x all pages,EPub Reformatted especially for book readers, Mobi For Kindle which was converted from the EPub file, Word, The original source document. Framework it unfortunately you decide!
Manage you tracing to obtain Endodoncia, irrigantes y su eficacia antibacteriana: Estudio in vitro: Extracto de Caesalpinia Spinosa 100% e book?
Is that this ebook effect the subscribers forthcoming? Of module yes. This book gives the readers many references and knowledge that bring positive influence in the future. It gives the readers good spirit. Although the content of this book aredifficult to be done in the real life, but it is still give good idea. It makes the readers feel enjoy and still positive thinking. This book really gives you good thought that will very influence for the readers future. How to get thisbook? Getting this book is simple and easy. You can download the soft file of this book in this website. Not only this book entitled Endodoncia, irrigantes y su eficacia antibacteriana: Estudio in vitro: Extracto de Caesalpinia Spinosa 100% e By Adriana Haro Valencia, Raquel Guillen, you can also download other attractive online book in this website. This website is available with pay and free online books. You can start in searching the book in titled Endodoncia, irrigantes y su eficacia antibacteriana: Estudio in vitro: Extracto de Caesalpinia Spinosa 100% ein the search menu. Then download it. Plan for few minute until the obtain is finish. This padded record is set to study whilst you aim.
Endodoncia, irrigantes y su eficacia antibacteriana: Estudio in vitro: Extracto de Caesalpinia Spinosa 100% e By Adriana Haro Valencia, Raquel Guillen PDF
Endodoncia, irrigantes y su eficacia antibacteriana: Estudio in vitro: Extracto de Caesalpinia Spinosa 100% e By Adriana Haro Valencia, Raquel Guillen Epub
Endodoncia, irrigantes y su eficacia antibacteriana: Estudio in vitro: Extracto de Caesalpinia Spinosa 100% e By Adriana Haro Valencia, Raquel Guillen Ebook
Endodoncia, irrigantes y su eficacia antibacteriana: Estudio in vitro: Extracto de Caesalpinia Spinosa 100% e By Adriana Haro Valencia, Raquel Guillen Rar
Endodoncia, irrigantes y su eficacia antibacteriana: Estudio in vitro: Extracto de Caesalpinia Spinosa 100% e By Adriana Haro Valencia, Raquel Guillen Zip
Endodoncia, irrigantes y su eficacia antibacteriana: Estudio in vitro: Extracto de Caesalpinia Spinosa 100% e By Adriana Haro Valencia, Raquel Guillen Read Online